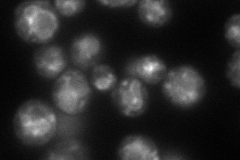
YAR027W
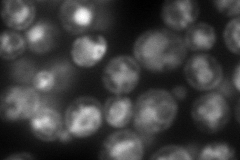
YAR027W
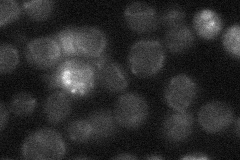
YAR027W
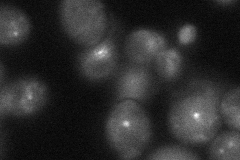
YAR027W
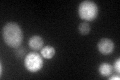
YAR027W

View description
Putative integral membrane protein of unknown function; interacts with Ulp1p at the nuclear periphery; member of DUP240 gene family
Localization:
Intensity:
Fold change:
Significance:
-
C’ GFP library in SD

ambiguous19.61 -
N' NOP1pr-GFP in SD
punctate,vacuole membrane118.1 -
N' TEF2pr-mCherry in SD
ER,vacuole235.893 -
N' NATIVEpr-GFP in SD
below threshold17.1342 -
N' TEF2pr-VC and Cyto-VN in SD
punctate39.2889 -
C’ GFP library in SD+DTT
ambiguous50.382.56No -
C’ GFP library in SD+H2O2

ambiguous19.590.99No -
C’ GFP library in Starvation Media

ambiguous47.162.4No -
C’ GFP library on the background of Pup2-DaMP

ambiguous -
C’ GFP library on the background of CCT mutant

ambiguous16.28970.830079No
